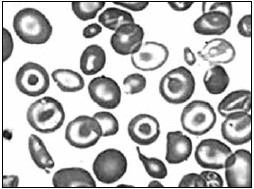
Enunciado 3519100-1

Foi solicitada uma curva de fragilidade osmótica a uma criança de 2 anos de idade, após a mãe descrever ao médico generalista a dificuldade de seu filho ter boa qualidade de vida devido às suas repetidas internações, quadros de infecções e anemia, sem sucesso após terapia com ferro. O esfregaço sanguíneo revelou poiquilocitose com presença de hemácias em alvo, hipocromia e anisocitose. Avaliando a curva de fragilidade osmótica, sugere-se um quadro de:
Figura 1
Figura 2

(Laudo e imagem cedidos pelo Laboratório de Análises Clínicas do Centro Universitário FMABC)
Provas
Questão presente nas seguintes provas
Médico - Patologia Clínica/Medicina Laboratorial
50 Questões